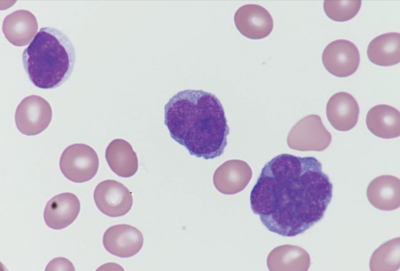
#

69歳の男性。1か月前からの皮膚紅斑および1週間前からの全身倦怠感と食欲不振を主訴に来院した。姉が血液疾患で死亡している。体温 37.1 ℃。脈拍 68/分、整。上半身に紅斑を認める。体表リンパ節は触知しない。
血液所見:赤血球 446万、Hb 14.9 g/dL、Ht 44%、白血球 14,800、血小板 20万。血液生化学所見:総蛋白 6.9 g/dL、アルブミン 4.1 g/dL、総ビリルビン 1.5 mg/dL、AST 95 U/L、ALT 53 U/L、LD 1,916 U/L(基準 120~245)、クレアチニン 1.4 mg/dL。末梢血塗抹May-Giemsa染色標本写真を別に示す。
この患者で注意すべき合併症はどれか。
a. 高リン血症
b. 高クロール血症
c. 高カルシウム血症
d. 高ナトリウム血症
e. 高マグネシウム血症